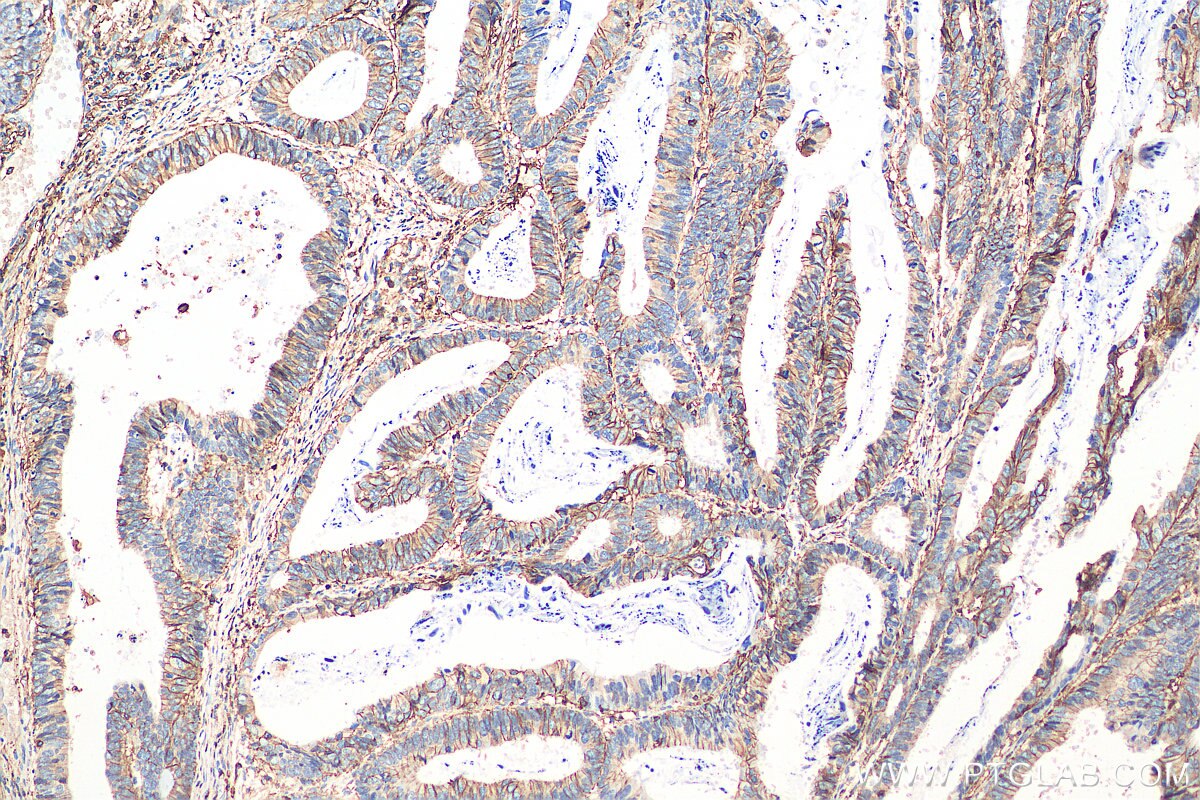

Can You Survive Stage 4 Lung And Brain Cancer Sep 9 2024 nbsp 0183 32 blk btl
What can i say Mamba out TV 888 I understand that the registration process is quite lengthy So if I can be of assistance in any way please do not hesitate to contact me Is there anything else that I can do to help expedite the
Can You Survive Stage 4 Lung And Brain Cancer
Can You Survive Stage 4 Lung And Brain Cancer
https://www.ptglab.com/Products/Pictures/CD44-Antibody-15675-1-AP-IHC-249149.jpg
:max_bytes(150000):strip_icc()/stage-4-cancer-5092070_color-b41add690efd427294f126c16723372c.jpg)
Stage 4 Cancer Definition Diagnosis Prognosis
https://www.verywellhealth.com/thmb/7DhYrIhFYD_EDDsiFvdnMgpBqeo=/1500x0/filters:no_upscale():max_bytes(150000):strip_icc()/stage-4-cancer-5092070_color-b41add690efd427294f126c16723372c.jpg

Is Stage 4 Lung Cancer Curable Survival Rates Treatment
https://www.lungcancercenter.com/app/uploads/2022/03/GettyImages-103046683-scaled.jpg
Are you ready kids Aye aye captain I can amp 39 t hear you Aye aye captain Ooh Who Booty Music Booty Music Deep Side Deep Side Deep Side When the beat goin like that boom boom Girl I wanna put you up
2011 1 Nov 1 2009 nbsp 0183 32 One thing you can be sure of I ll never ask for more than your love Nothing s gonna change my love for you
More picture related to Can You Survive Stage 4 Lung And Brain Cancer
:max_bytes(150000):strip_icc()/what-is-stage-4-lung-cancer-life-expectancy-2249420-FINAL-14afe9f201f04c64943bfc0f52854d2d.jpg)
Stage 4 Lung Cancer Life Expectancy
https://www.verywellhealth.com/thmb/UiU0ohU7W7801hyGIo5eEnt-HKY=/1500x0/filters:no_upscale():max_bytes(150000):strip_icc()/what-is-stage-4-lung-cancer-life-expectancy-2249420-FINAL-14afe9f201f04c64943bfc0f52854d2d.jpg
:max_bytes(150000):strip_icc()/what-is-stage-4-lung-cancer-life-expectancy-2249420_final1-5b42c03946e0fb003781c363.png)
Stage 4 Lung Cancer Life Expectancy
https://www.verywellhealth.com/thmb/s3T9U9rwp97GL45yIu3H9Z9Er7Y=/1500x0/filters:no_upscale():max_bytes(150000):strip_icc()/what-is-stage-4-lung-cancer-life-expectancy-2249420_final1-5b42c03946e0fb003781c363.png
:max_bytes(150000):strip_icc()/lung-cancer-5yr-chart-04-5b8558d3c9e77c00253444cb.png)
Stage 4 Lung Cancer Life Expectancy
https://www.verywellhealth.com/thmb/ARu-Qdr3xzcCZsN4vEhiKPOEf1I=/1500x0/filters:no_upscale():max_bytes(150000):strip_icc()/lung-cancer-5yr-chart-04-5b8558d3c9e77c00253444cb.png
Safari Safari can not pen the page github github github jetbrain github jetbrain
[desc-10] [desc-11]

Love For Lungs Olympus Medical Systems
https://www.olympus-europa.com/medical/rmt/media/Content/Content-MSD/Images/Landingpages/LungCancerAwareness/Lung-Cancer-Awareness-Month_5-Year-Survival-Rate_750x573_EN_v01.jpg

Can You Survive Stage 4 Lung Cancer
https://www.nejm.org/na101/home/literatum/publisher/mms/journals/content/nejm/1965/nejm_1965.272.issue-11/nejm196503182721104/20130805/images/img_medium/nejm196503182721104_f4.jpeg
Can You Survive Stage 4 Lung And Brain Cancer - [desc-13]